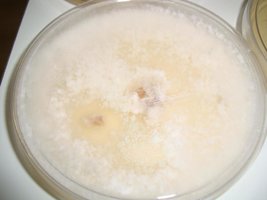

M
Mauricio
Visitante
Abri esse tópico para que vocês coloquem perguntas sobre o que querem saber sobre cultivo em geral.
Então as perguntas, ainda não discutidas, serão analisadas e faremos um resumo para postar aqui:
https://teonanacatl.org/threads/reiniciando-o-início.4869/#post-83545
Com o progresso teremos o tópico, do link acima, com todas as questões, assim é fácil apontá-lo para um membro novato que tiver as mesmas dúvidas.
A vantagem é não congestionar o forúm com perguntas repetidas, que quase sempre têem o caminho da lixeira.
Dúvidas ?
Então as perguntas, ainda não discutidas, serão analisadas e faremos um resumo para postar aqui:
https://teonanacatl.org/threads/reiniciando-o-início.4869/#post-83545
Com o progresso teremos o tópico, do link acima, com todas as questões, assim é fácil apontá-lo para um membro novato que tiver as mesmas dúvidas.
A vantagem é não congestionar o forúm com perguntas repetidas, que quase sempre têem o caminho da lixeira.
Dúvidas ?